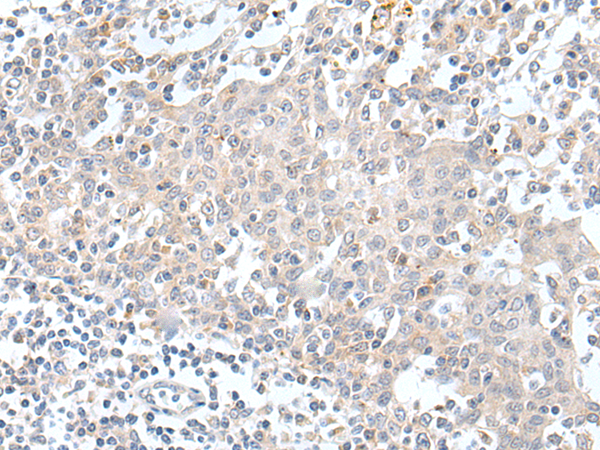

-
分类: 科研抗体货号: P12669别名: Pr; pr1/Pr2; PRP-1/PRP-2应用: WB,IHC反应种属: Human
-
分类: 科研抗体货号: P12648别名: TL6; AITRL; GITRL; TNLG2A; hGITRL应用: IHC反应种属: Human
-
分类: 科研抗体货号: P12661别名:应用: IHC反应种属: Human, Mouse, Rat
-
分类: 科研抗体货号: P12668别名: HOX1; ABD-B; HOX1G; HOX1.7应用: WB,IHC反应种属: Human, Mouse
-
分类: 科研抗体货号: P12690别名:应用: IHC反应种属: Human, Mouse
-
分类: 科研抗体货号: P12659别名: FH; HF; HF1; HF2; HUS; FHL1; AHUS1; AMBP1; ARMD4; ARMS1; CFHL3应用: WB反应种属: Human
-
分类: 科研抗体货号: P12667别名: HOX1; HOX1C; HOX1.3应用: IHC反应种属: Human, Mouse, Rat
-
分类: 科研抗体货号: P12689别名: HAK应用: IHC反应种属: Human
-
分类: 科研抗体货号: P12658别名: EAG; EAG1; TMBTS; h-eag; Kv10.1应用: IHC反应种属: Human, Mouse, Rat
-
分类: 科研抗体货号: P12666别名: UFS; HPA2; HPR2; UFS1应用: WB,IHC反应种属: Human, Mouse

鄂公网安备42018502007531号
鄂公网安备42018502007531号

